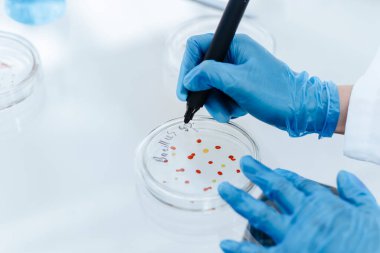
Kapat. Bilim adamı virüs bakterisiyle bir Petri kabını işaretliyor.

Doktor, pipetten idrar damlatarak test şeridi testine ya da idrar enfeksiyonuna karşı labirente giriyor. Protein, lökosit, Uroikojen, Bilirubin, Kan, Nitrit, pH analizi için tıbbi laboratuvarda idrar testi.
İhlal Bildirim Formu
Özel Boyut
(5300 x 3533, jpg)
Geniş Lisanslama
(5300 x 3533, jpg)
* Kurumsal aylık abonelikte çok avantajlı fiyatlar için tıklayın.
* Fiyatlara Kdv dahil değildir.
Örnek Kullanımlar: Web siteleri; reklam afişleri; ekran koruyucuları; sunumlar (PowerPoint, Flash, vs); filmler, videolar veya televizyon reklamları, gazete ve dergilerdeki reklamlar, bastırılmış reklam materyalleri; kitaplar için kapak, iş kartları; el ilanları; posterler; CD/DVD kapakları, etiketler veya ürün paketleri, kırtasiye, dosya, defterler, tükenmez kalem, kalemler, yapıştırmalar; takvimler; fincanlar veya bardaklar; fare altlığı; tişörtler, kıyafet vs. Detaylı Tablo için Tıklayınız!
En Çok Aranan Kelimeler
donanımkişiSağlıkProteinİlaçTıbbiteknolojiKlinikDoktorHastaneSınavincelenmesiprofesyonelTest etTüpTedaviHastalıkörnekKimyasalDeneyLaboratuvarBilimanalizBiyokimyasalaraştırmaBilimselkontrol etTeşhisİncelemebiyokimyabilim adamıSağlıkçıEnfeksiyonBöbrekŞeker hastasıdiyabetCheck upÜrolojiSağlık hizmetleriBenzer İçerikler


Özel Boyut
(5300 x 3533, jpg)
Geniş Lisanslama
(5300 x 3533, jpg)
Eser Sahibi:
Tarih:
Warning: substr_count(): Empty substring in /home/lisansio/public_html/wp-content/themes/telifport_v3/inc-frontend/modal-urun-bilgileri.php on line 288